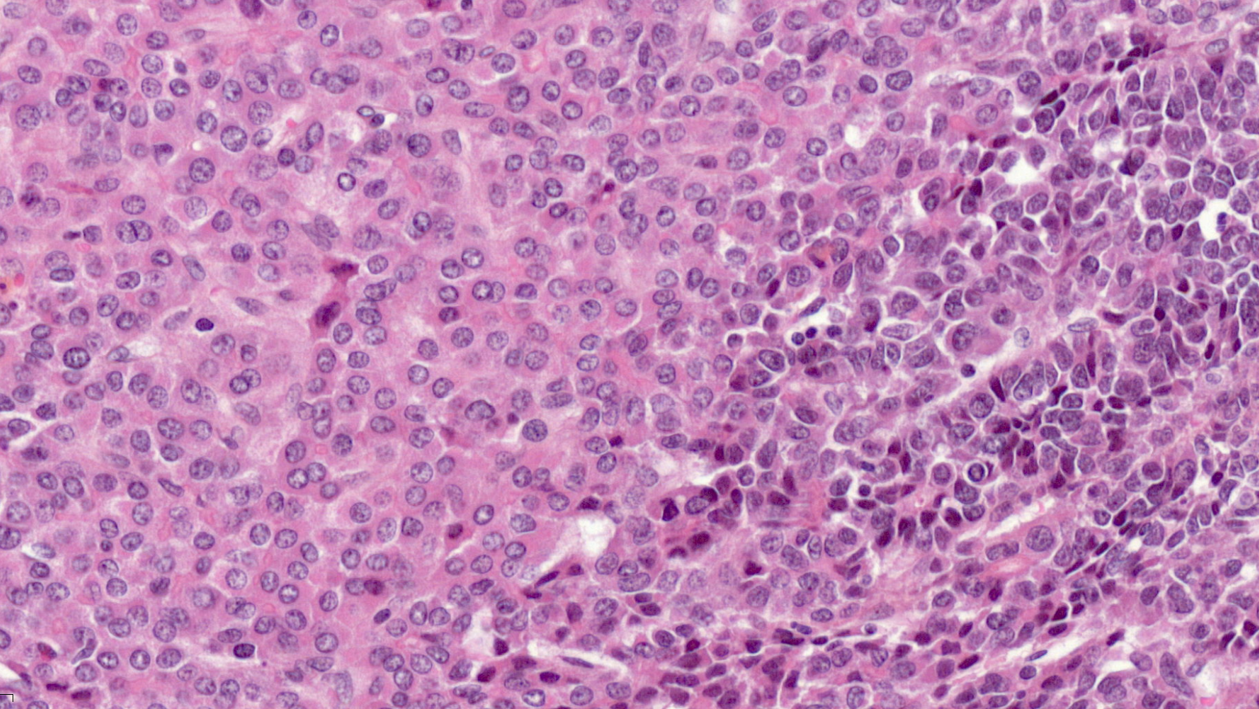

Grâce à une importante analyse génomique des cancers du foie de l’enfant, l’équipe du Professeure Jessica Zucman-Rossi au Centre de Recherche des Cordeliers (Université Paris Cité, Inserm, Sorbonne Université), et ses collaborateurs du réseau Hepatobio, ont identifié de nouveaux mécanismes de résistance à la chimiothérapie. Les résultats, publiés en avril 2021 dans le très prestigieux journal Cancer Discovery, permettent non seulement une meilleure compréhension des mécanismes d’initiation et de progression des tumeurs du foie de l’enfant, mais surtout d’envisager de nouvelles options thérapeutiques pour les malades résistants à la chimiothérapie.
Diversité de cellules au sein d’une même tumeur. Visualisation au microscope (avec une coloration à l’hématoxyline et à l’éosine) pour des hépatoblastomes, inclus dans l’étude.
© Dr Guillaume Morcrette
Les cancers du foie, qui représentent environ 1% de l’ensemble des tumeurs de l’enfant, constituent un groupe rare et hétérogène dont les caractéristiques moléculaires et cliniques ne sont pas encore bien comprises. L’hépatoblastome est le type de tumeur maligne hépatique le plus fréquent chez l’enfant, avec une incidence d’un cas pour un million d’enfants de moins de 15 ans, soit 10 à 15 nouveaux cas par an en France, survenant principalement avant l’âge de 2 ans.
L’hépatoblastome est généralement une tumeur de bon pronostic, avec une guérison d’environ 80% des enfants 5 ans après le diagnostic grâce aux traitements qui reposent sur une combinaison chimiothérapie/chirurgie. Cependant, des résistances à la chimiothérapie surviennent chez environ un enfant sur 5, et les alternatives thérapeutiques sont alors limitées. Il est donc essentiel d’approfondir nos connaissances des mécanismes d’initiation et de progression de ces tumeurs pour améliorer la prise en charge des patients en termes de diagnostic, de pronostic et de thérapie.
L’équipe du Professeure Zucman-Rossi, pionnière dans ce domaine, a effectué une analyse dite « multi-omique intégrée » de près de 130 tumeurs hépatocellulaires pédiatriques. Cette analyse, qui repose sur plusieurs approches, a permis aux chercheurs de caractériser de nouvelles mutations à l’origine du développement des hépatoblastomes, et de comprendre l’origine de la résistance de certaines tumeurs à la chimiothérapie.
Dans leur première approche, l’analyse génomique, les chercheurs ont, pour chaque patient, réalisé le séquençage de l’ensemble du génome des cellules cancéreuses et l’ont comparé aux séquences d’ADN des cellules contenues dans la partie non tumorale du foie. Ceci a permis d’identifier les mutations génétiques responsables du développement des tumeurs.
Cette analyse génomique a révélé des altérations fréquentes d’une région du chromosome 11 (le locus 11p15) responsable de la surexpression de l’oncogène IGF2 et qui est associée au développement des tumeurs. Cette altération du chromosome 11 a également été retrouvée dans des petits groupes de cellules (îlots cellulaires) dispersés dans la partie non-tumorale du foie, et ce chez 10% des patients atteints d’hépatoblastomes. Ce résultat suggère que ces îlots cellulaires constitueraient des zones pré-tumorales et seraient un terrain favorable au développement d’un hépatoblastome.
Parallèlement, les chercheurs ont montré que, dans quasiment tous les cas, la transformation maligne en cancer était liée à l’activation de l’oncogène ß-caténine associée à des mutations rares d’autres gènes (NFE2L2, TERT, GPC3, RPS6KA3 ou CREBBP).
La deuxième approche, l’analyse transcriptomique, repose sur l’analyse de l’expression des gènes grâce aux ARN messagers qu’ils produisent. Cette analyse a permis aux chercheurs de mettre en évidence l’extraordinaire plasticité des cellules tumorales dans les hépatoblastomes. Plasticité qui n’est pas sans conséquence pour l’évolution des hépatoblastomes.
En effet, alors que la plupart des cellules cancéreuses d’une tumeur présentent les mêmes mutations génétiques, les chercheurs ont montré qu’il peut exister quatre sous-populations cellulaires au sein d’une même tumeur. Elles se caractérisent par les différents types de gènes qu’elles expriment (stade de différentiation), leur niveau de prolifération et d’infiltration par des cellules immunitaires. L’une de ces populations contient des cellules bloquées à un stade précoce de leur développement, appelées « cellules de type progéniteur ». Les chercheurs ont montré que cette population de cellules accumule des mutations génétiques lors de l’exposition au cisplatine, molécule faisant partie de la chimiothérapie, et que cette accumulation de mutations est associée à la résistance à la chimiothérapie et donc aux rechutes après chimiothérapie. La présence de ce type de cellules au sein de la tumeur primaire (tumeur initiale) est donc un marqueur de moins bon pronostic et de résistance aux traitements classiques.
En cherchant à cibler spécifiquement ces cellules de type ‘progéniteur’, l’équipe a pu identifier de nouveaux traitements candidats permettant de surmonter la résistance au cisplatine dans des expériences in vitro et chez la souris, qui restent à confirmer chez les patients.
Grâce à la caractérisation précise de la diversité moléculaire et génomique des tumeurs du foie pédiatriques, cette étude permet non seulement de mieux comprendre l’origine du développement des cancers, les phénomènes de plasticité cellulaire à l’origine des cas de résistance mais également d’explorer de nouvelles pistes thérapeutiques afin de proposer un traitement aux enfants qui ne répondent pas à la chimiothérapie.
Ce travail a été soutenu financièrement par : la SFCE, l’association Etoile de Martin, la Fédération Enfants et Santé (FES), l’association Hubert Gouin « Enfance et Cancer », l’Inca, la Ligue Nationale contre le Cancer (Equipe Labellisée), le Coup d’Elan de la Fondation Bettencourt-Schueller, la Fondation d’Entreprise Bristol-Myers Squibb, le SIRIC CARPEM, la FRM prix Rosen, la Ligue Contre le Cancer Comité de Paris (prix René et André Duquesne) et la Fondation Mérieux.
Référence
Integrated genomic analysis identifies driver genes and cisplatin-resistant progenitor phenotype in pediatric liver cancer, Theo Z Hirsch1*, Jill Pilet1*, Guillaume Morcrette1,2*, Amélie Roehrig1, Benedict JE Monteiro1, Laura Molina1,3, Quentin Bayard1, Eric Trépo1,4, Léa Meunier1, Stefano Caruso1, Victor Renault5, Jean-François Deleuze5,6, Brice Fresneau7, Christophe Chardot8, Emmanuel Gonzales9, Emmanuel Jacquemin9, Florent Guerin10, Monique Fabre11, Isabelle Aerts12, Sophie Taque13, Véronique Laithier14, Sophie Branchereau15, Catherine Guettier16, Laurence Brugières7, Sandra Rebouissou1, Eric Letouzé1** & Jessica Zucman-Rossi1,17**.
In Press Cancer Discovery 2021, Accepted April 21st, 2021
Contacts
Pr Jessica ZUCMAN-ROSSI, PU-PH Université Paris Cité – Hôpital Européen Georges Pompidou (AP-HP) – Directrice du Centre de Recherche des Cordeliers – UMRS1138
Dr Éric LETOUZÉ, Chercheur Inserm – Centre de Recherche des Cordeliers – UMRS1138
À lire aussi

Prix Irène Joliot-Curie 2024 : Marie Verbanck récompensée
Créé en 2001 par le Ministère de l’Enseignement supérieur et de la Recherche, le prix Irène Joliot-Curie récompense chaque année des femmes qui se distinguent par la qualité de leurs recherches dans l’univers des sciences, de la recherche et de la technologie....

Les bactériophages, vers une alternative ciblée aux antibiotiques
Avec l’essor des antibiotiques dans les années 1930, la phagothérapie a été abandonnée. Aujourd’hui, la montée de l’antibiorésistance rend le traitement des infections bactériennes de plus en plus difficile et la phagothérapie suscite à nouveau l’intérêt des médecins...

26 Highly Cited Researchers 2024 : 26 citations pour l’université Paris Cité
Avec 26 mentions en première affiliation, l’université Paris Cité assoit sa position qui confirme l’influence de sa communauté de recherche au niveau mondial. Université Paris Cité félicite ces 26 highly cited researchers. Lire la suite 26 Highly Cited Researchers 2024 : 26 citations pour l’université Paris Cité
![[Retour sur la conférence La Guilde] L’Intelligence artificielle dans l’enseignement supérieur et la recherche : débats et perspectives](https://wordpress-test.app.u-pariscite.fr/wp-content/uploads/2024/11/Allassonniere_Loupy_1920-1-1080x675.jpg)
[Retour sur la conférence La Guilde] L’Intelligence artificielle dans l’enseignement supérieur et la recherche : débats et perspectives
Le 6 novembre 2024, l’université Paris Cité et l’Université PSL ont réuni les communautés des universités membres du réseau La Guilde lors d’un événement consacré à l’intelligence artificielle et son impact sur les universités, au sein du PariSanté Campus. Stéphanie...
